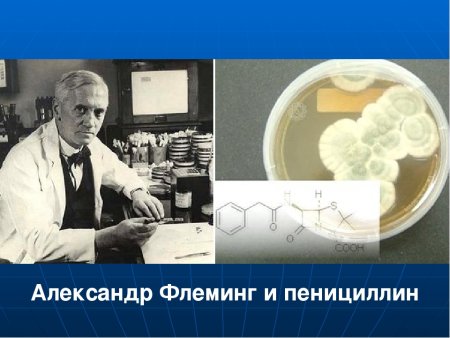
Александр Флеминг лизоцим
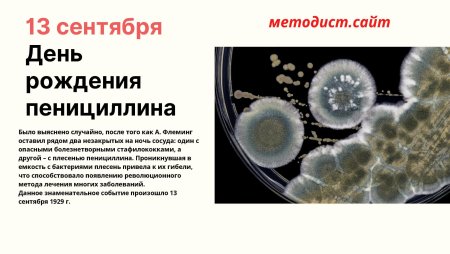
День пенициллина 13 сентября
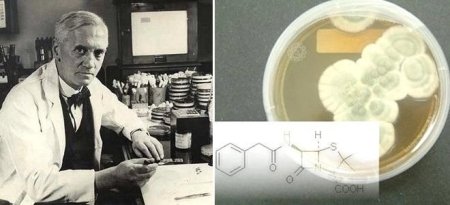
Александр Флеминг фото в молодости
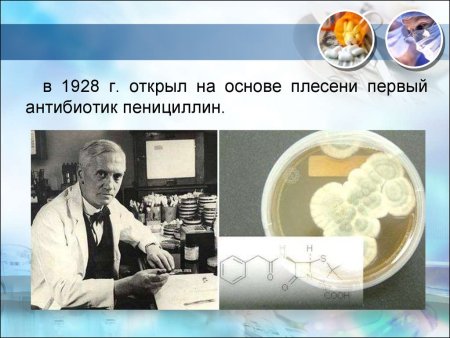
В 1928 Г. Александр Флеминг открыл пенициллин
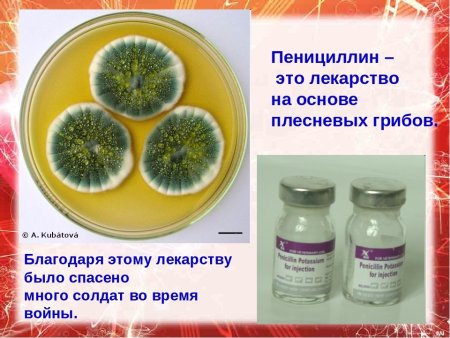
Антибиотики из плесени
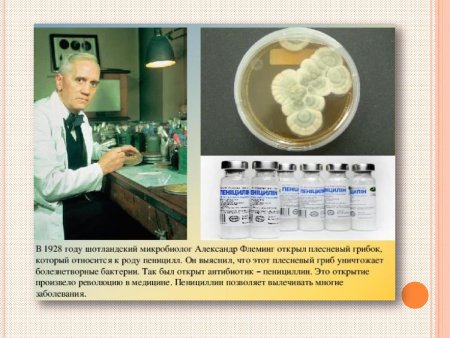
В 1928 Г. Александр Флеминг открыл пенициллин
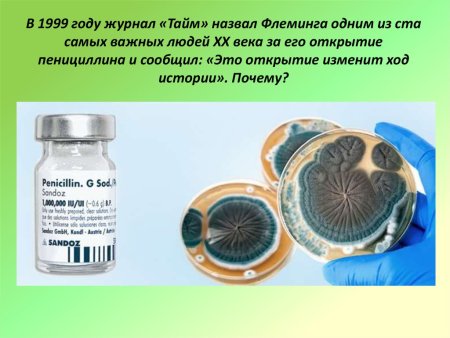

Подготовьтесь к празднику День рождения пенициллина с нашей коллекцией рисунков для срисовки! Идеально подходящие для творческих мероприятий, эти рисунки представляют различные изображения пенициллина в уникальных стилях и позах. Разукрасьте их по своему вкусу, добавьте яркие цвета и создайте красочное настроение на вечеринке. Наша коллекция рисунков для срисовки поможет вам оживить День рождения пенициллина и сделать его запоминающимся для всех гостей!
![Флеминг пенициллин презентация]()
Флеминг пенициллин презентация
![Пенициллин формула химическая]()
Пенициллин формула химическая
![Пеницилл рисунок]()
Пеницилл рисунок
![День рождения пенициллина 13 сентября]()
День рождения пенициллина 13 сентября
![В 1928 Г. Александр Флеминг открыл пенициллин]()
В 1928 Г. Александр Флеминг открыл пенициллин
![Пенициллиновый бульон]()
Пенициллиновый бульон
![]()
![Научные открытия 20 века антибиотик пенициллин]()
Научные открытия 20 века антибиотик пенициллин
![Александр Флеминг лизоцим]()
Александр Флеминг лизоцим
![День пенициллина 13 сентября]()
День пенициллина 13 сентября
![Пенициллин информация]()
Пенициллин информация
![Пенициллин 1942]()
Пенициллин 1942
![Александр Флеминг фото в молодости]()
Александр Флеминг фото в молодости
![Год открытия пенициллина Флемингом]()
Год открытия пенициллина Флемингом
![Benzylpenicillin narxi]()
Benzylpenicillin narxi
![]()
![Пеницилл антибиотики рисунок]()
Пеницилл антибиотики рисунок
![]()
![Дудлы гугла ученый 10]()
Дудлы гугла ученый 10
![]()
![В 1928 Г. Александр Флеминг открыл пенициллин]()
В 1928 Г. Александр Флеминг открыл пенициллин
![День рождения пенициллина]()
День рождения пенициллина
![Открытие антибиотиков (а. Флеминг, э. чейн и у. Флори, з.в. Ермольева).]()
Открытие антибиотиков (а. Флеминг, э. чейн и у. Флори, з.в. Ермольева).
![День рождения пенициллина 13 сентября]()
День рождения пенициллина 13 сентября
![Александр Флеминг искусство]()
Александр Флеминг искусство
![Penicillium marneffei мазок]()
Penicillium marneffei мазок
![Антибиотики пенициллин Флеминг]()
Антибиотики пенициллин Флеминг
![Антибиотики пенициллин Флеминг]()
Антибиотики пенициллин Флеминг
![Рисование бактериями Флеминг]()
Рисование бактериями Флеминг
![Пенициллин грибок иллюстрация]()
Пенициллин грибок иллюстрация
![Пенициллин вектор]()
Пенициллин вектор
![Антибиотик 1928 Флеминг]()
Антибиотик 1928 Флеминг
![Открытие пенициллина кратко]()
Открытие пенициллина кратко
![Антибиотики проект по химии]()
Антибиотики проект по химии
![Антибиотики из плесени]()
Антибиотики из плесени
![Пенициллин рисунок биология]()
Пенициллин рисунок биология
![Leo фарм]()
Leo фарм
![Пенициллин без фона]()
Пенициллин без фона
![В 1928 Г. Александр Флеминг открыл пенициллин]()
В 1928 Г. Александр Флеминг открыл пенициллин
![Александр Флеминг пенициллин Нобелевская премия]()
Александр Флеминг пенициллин Нобелевская премия
![]()
![Пенициллин рисунок]()
Пенициллин рисунок

Grizly.club
Grizly.club


